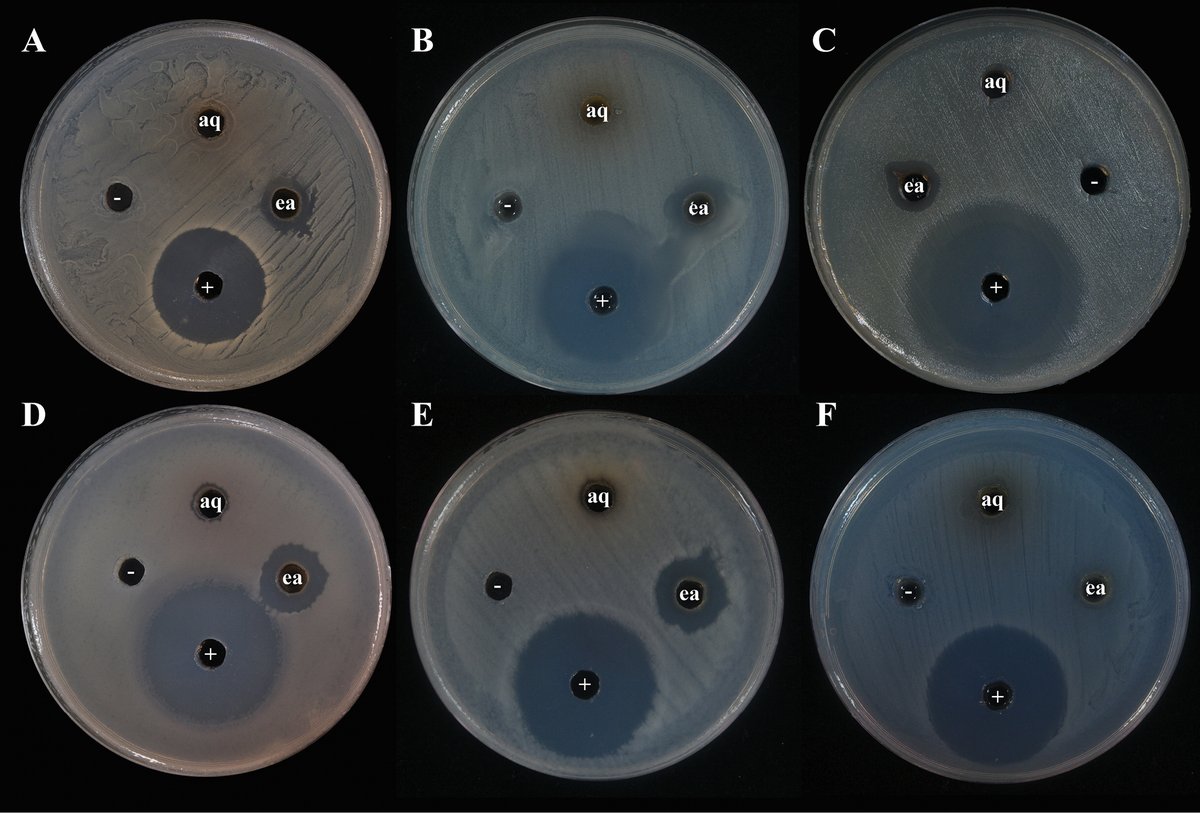
MycoKeys tweet media
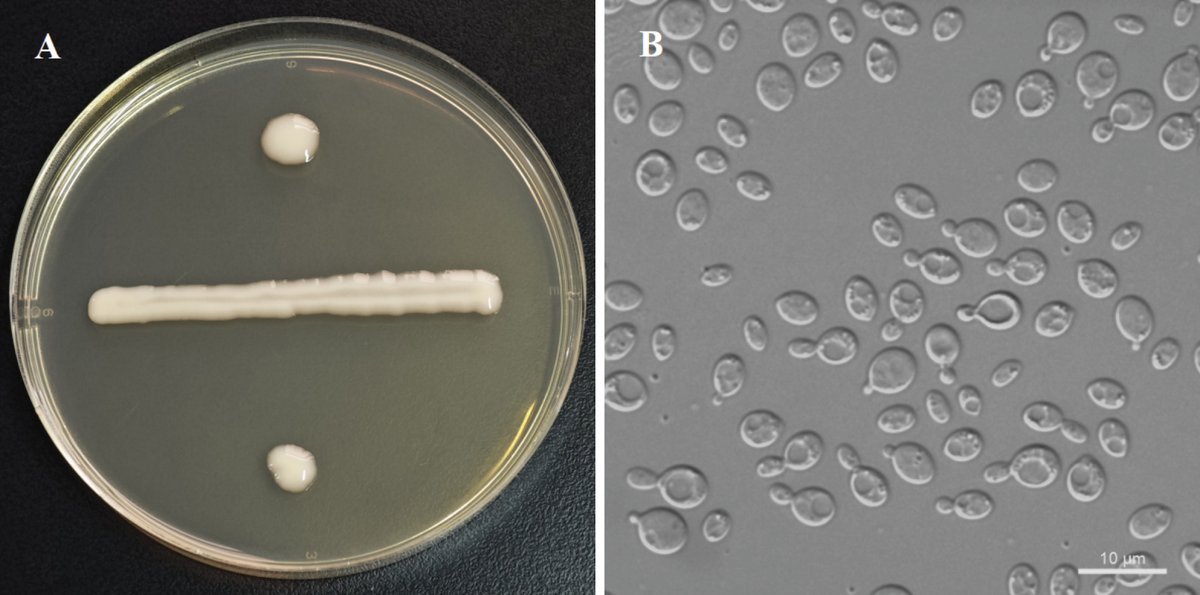
MycoKeys tweet media

Four new species of leaf-dwelling yeasts are described from China, including an entirely new genus named Lumyongozyma.
These findings reveal that this group of colorful fungi is far more diverse and geographically widespread than previously known: doi.org/10.3897/mycoke…

English